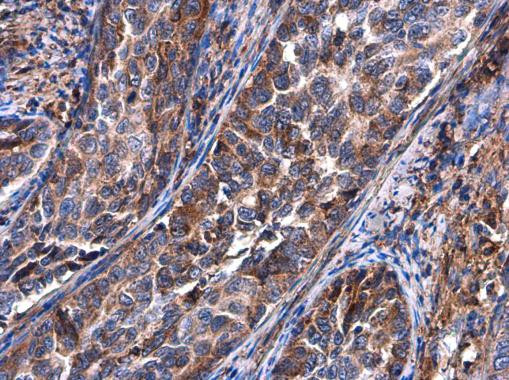
BASP1 Antibody in Immunohistochemistry (Paraffin) (IHC (P))

Search
Invitrogen
BASP1 Polyclonal Antibody
{{$productOrderCtrl.translations['antibody.pdp.commerceCard.promotion.promotions']}}
{{$productOrderCtrl.translations['antibody.pdp.commerceCard.promotion.viewpromo']}}
{{$productOrderCtrl.translations['antibody.pdp.commerceCard.promotion.promocode']}}: {{promo.promoCode}} {{promo.promoTitle}} {{promo.promoDescription}}. {{$productOrderCtrl.translations['antibody.pdp.commerceCard.promotion.learnmore']}}
图: 1 / 5
BASP1 Antibody (PA5-78320) in IHC (P)





产品信息
PA5-78320
种属反应
宿主/亚型
分类
类型
抗原
偶联物
形式
浓度
规格
纯化类型
保存液
内含物
保存条件
运输条件
RRID
产品详细信息
Positive Control: 293T, A431, HeLa, U87-MG, SK-N-SH, IMR32, SK-N-AS
Predicted Reactivity: Zebrafish (82%), Xenopus laevis (80%)
Store product as a concentrated solution. Centrifuge briefly prior to opening the vial.
靶标信息
BASP1 (brain acid soluble protein 1) is a membrane bound protein with several transient phosphorylation sites and PEST motifs. Conservation of proteins with PEST sequences among different species supports their functional significance. PEST sequences typically occur in proteins with high turnover rates. Immunological characteristics of this protein are species specific. This protein also undergoes N-terminal myristoylation.
仅用于科研。不用于诊断过程。未经明确授权不得转售。
篇参考文献 (0)
生物信息学
蛋白别名: 22 kDa neuronal tissue-enriched acidic protein; Brain acid soluble protein 1; brain acid-soluble protein 1; brain acidic membrane protein; cytoskeleton associated protein 3; MGC8555; NAP-22; Neuronal axonal membrane protein NAP-22; neuronal tissue-enriched acidic protein; unnamed protein product
基因别名: 2610024P12Rik; BASP1; CAP-23; CAP23; Ckap3; NAP-22; NAP22
UniProt ID: (Human) P80723, (Mouse) Q91XV3, (Rat) Q05175
Entrez Gene ID: (Human) 10409, (Mouse) 70350, (Rat) 64160